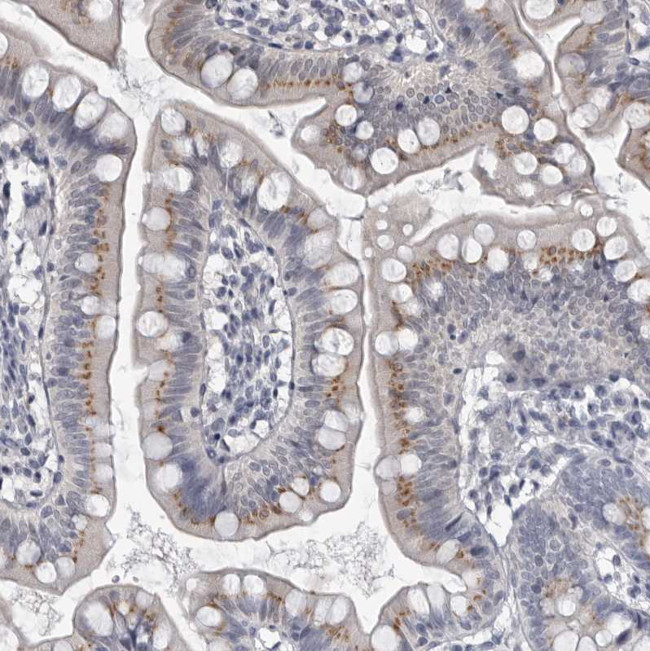
MYOC Antibody in Immunohistochemistry (Paraffin) (IHC (P))

Search
Invitrogen
MYOC Polyclonal Antibody
{{$productOrderCtrl.translations['antibody.pdp.commerceCard.promotion.promotions']}}
{{$productOrderCtrl.translations['antibody.pdp.commerceCard.promotion.viewpromo']}}
{{$productOrderCtrl.translations['antibody.pdp.commerceCard.promotion.promocode']}}: {{promo.promoCode}} {{promo.promoTitle}} {{promo.promoDescription}}. {{$productOrderCtrl.translations['antibody.pdp.commerceCard.promotion.learnmore']}}
产品信息
PA5-55590
种属反应
宿主/亚型
分类
类型
抗原
偶联物
形式
浓度
规格
纯化类型
保存液
内含物
保存条件
运输条件
RRID
产品详细信息
Immunogen sequence: NLLRDKSVLE EEKKRLRQEN ENLARRLESS SQEVARLRRG QCPQTRDTAR AVPPGSREVS TWNLDTLAFQ ELKSELTEVP ASRIL
Highest antigen sequence identity to the following orthologs: Mouse - 79%, Rat - 79%.
靶标信息
Myocilin is an extracellular protein expressed in the eye, including the retina, trabecular meshwork and ciliary body. Myocilin can form homomultimers in vivo and can also associate with components of the ECM via interactions with the Hep II domain of FibroPVRL1. In addition, myocilin interacts with myosin regulatory light chain, a component of the myosin motor protein complex. This interaction implies a role for myocilin in the actomyosin system, linking myocilin to the functional status of the trabecular meshwork (TM), which is responsible for controlling the intraocular pressure (IOP). Alterations in functions of the TM may lead to IOP elevation and development of glaucoma, a major cause of blindness. Myocilin is encoded by MYOC (also designated TIGR), a gene that maps to the GLC1A locus on chromosome 1q24. 3 and is susceptible to mutations. Mutations in the MYOC gene are specifically linked with primary open angle glaucoma (POAG), a blinding disease characterized by progressive loss of retinal ganglion cells.
仅用于科研。不用于诊断过程。未经明确授权不得转售。
篇参考文献 (0)
生物信息学
蛋白别名: juvenile-onset open-angle glaucoma 1; mutated trabecular meshwork-induced glucocorticoid response protein; Myocilin; Myocilin 55 kDa subunit; myocilin protein; myocilin trabecular meshwork inducible glucocorticoid response protein; trabecular meshwork inducible glucocorticoid response protein; Trabecular meshwork-induced glucocorticoid response protein; unnamed protein product
基因别名: GLC1A; GPOA; JOAG; JOAG1; MYOC; TIGR
UniProt ID: (Human) Q99972
Entrez Gene ID: (Human) 4653